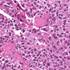

A 28-year-old male has suffered from fever of unknown origin, high blood pressure, diarrhea, and rapid heart rate for several years. Examination revealed enlarged cervical lymph nodes and thyroid nodularity. A biopsy was taken, as were several blood tests. After determining he carried a specific genetic mutation he was diagnosed with Sipple syndrome (MEN-2B). Click here to see the whole slide image.
A mutation in what gene was found?